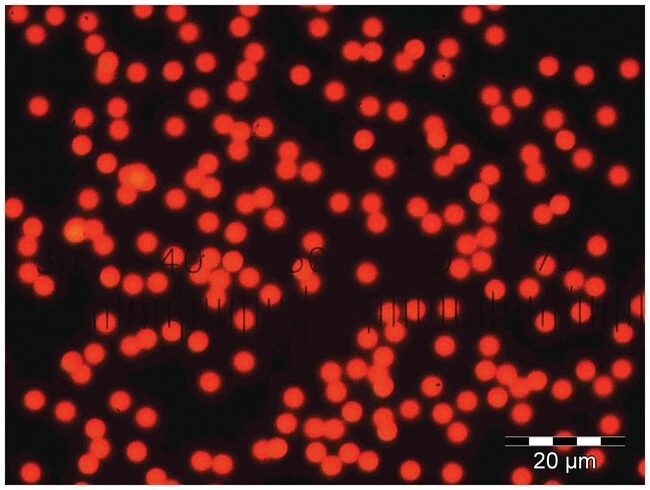
Main Image

Fluoro-Max Green and Red Dry Fluorescent Particles
Location:
New York, US
Condition:
New
Manufacturer:
Model:
36-11B
Warranty:
Yes
Categories:
Location:
New York, US
Condition:
New
Manufacturer:
Model:
36-11B
Warranty:
Yes
Categories:
resources
Shipping Information
Location:
New York, US
Thermo Fisher Scientific - Supplies & Plastic
New York, US
LabX Member Since December 13th, 2019
Thermo Fisher Scientific Inc. is the world leader in serving science, with annual revenue of approximately $40 billion. Our Mission is to enable our customers to make the world healthier, cleaner and safer. Whether our customers are accelerating life sciences research, solving complex analytical challenges, increasing productivity in their laboratories, improving patient health through diagnostics or the development and manufacture of life-changing therapies, we are here to support them. Our global team of more than 100,000 colleagues delivers an unrivaled combination of innovative technologies, purchasing convenience and pharmaceutical services through our industry-leading brands, including Thermo Scientific, Applied Biosystems, Invitrogen, Fisher Scientific, Unity Lab Services, Patheon and PPD. For more information, please visit www.thermofisher.com.
Listing SKU: DIS-150375-36-11B
Date Listed: April 10th, 2024
Last Updated: November 1st, 2025
Please Inquire for Price
See Shipping Information
My List
Create New List
Listing SKU: DIS-150375-36-11B
Date Listed: April 10th, 2024
Last Updated: November 1st, 2025
Listing SKU: DIS-150375-36-11B
Date Listed: April 10th, 2024
Last Updated: November 1st, 2025
More From Thermo Fisher Scientific - Supplies & Plastic
 Round Visotubes
Round Visotubes
 Locator Cryogenic Rack and Box Systems
Locator Cryogenic Rack and Box Systems
 Nunc CryoTube Colored Caps
Nunc CryoTube Colored Caps
 Nalgene Oak Ridge High-Speed Centrifuge Tubes made with Teflon fluoropolymer and Closure made with Tefzel
Nalgene Oak Ridge High-Speed Centrifuge Tubes made with Teflon fluoropolymer and Closure made with Tefzel
 WebSeal 96-Round Well Microplate Dome Base Silicone/PTFE Coated Sealing Mat, dk. blue
WebSeal 96-Round Well Microplate Dome Base Silicone/PTFE Coated Sealing Mat, dk. blue
 Nunc Cryobank and Bank-It Freezer Rack
Nunc Cryobank and Bank-It Freezer Rack
 Cryo Vial Closure Color Coders
Cryo Vial Closure Color Coders
 Multisip Septum Mat, 384-well
Multisip Septum Mat, 384-well
 CryoExtra High-Efficiency Cryogenic Storage Systems
CryoExtra High-Efficiency Cryogenic Storage Systems
 SureSTART WebSeal 96-Well Plate Sealing Mats, 7 mm Diameter, Round, Level 2 High-Throughput Applications
SureSTART WebSeal 96-Well Plate Sealing Mats, 7 mm Diameter, Round, Level 2 High-Throughput Applications
 SureSTART WebSeal 96-Well Plate Sealing Mats, 5.6 mm Diameter, Round, Level 2 High-Throughput Applications
SureSTART WebSeal 96-Well Plate Sealing Mats, 5.6 mm Diameter, Round, Level 2 High-Throughput Applications
 Arctic Express Transport Systems
Arctic Express Transport Systems
 Abgene SmartCap Mats
Abgene SmartCap Mats
 VersiCap Mat, 96-well, flat cap strips
VersiCap Mat, 96-well, flat cap strips
 SureSTART WebSeal 384-Well Plate Sealing Mat, Square, Level 1 Everyday Analysis
SureSTART WebSeal 384-Well Plate Sealing Mat, Square, Level 1 Everyday Analysis
 SureSTART WebSeal 96-Well Plate Sealing Mats, 8 mm Diameter, Square, Level 1 Everyday Analysis
SureSTART WebSeal 96-Well Plate Sealing Mats, 8 mm Diameter, Square, Level 1 Everyday Analysis
 SureSTART WebSeal 96-Well Plate Sealing Mats for Well Plate Kits, Level 3 High Performance Applications
SureSTART WebSeal 96-Well Plate Sealing Mats for Well Plate Kits, Level 3 High Performance Applications
 CryoPlus Storage Systems
CryoPlus Storage Systems
 VersiCap Mat, 96-well, ultra clear cap strips
VersiCap Mat, 96-well, ultra clear cap strips
 Arctic Express Cryogenic Shippers with Datalogger
Arctic Express Cryogenic Shippers with Datalogger
 Matrix Open-Top Tri-coded Tubes
Matrix Open-Top Tri-coded Tubes
 Linear Barcoded Tubes
Linear Barcoded Tubes
 CryoPlus Vapor Phase Starter Packages
CryoPlus Vapor Phase Starter Packages
 Thermo Series Liquid Nitrogen Transfer Vessels
Thermo Series Liquid Nitrogen Transfer Vessels
 Bio-Cane Cane and Canister Systems
Bio-Cane Cane and Canister Systems
Become a member and enjoy exclusive benefits
Create an account now for exclusive benefits, personalized recommendations, and seamless order tracking. Elevate your lab experience today!